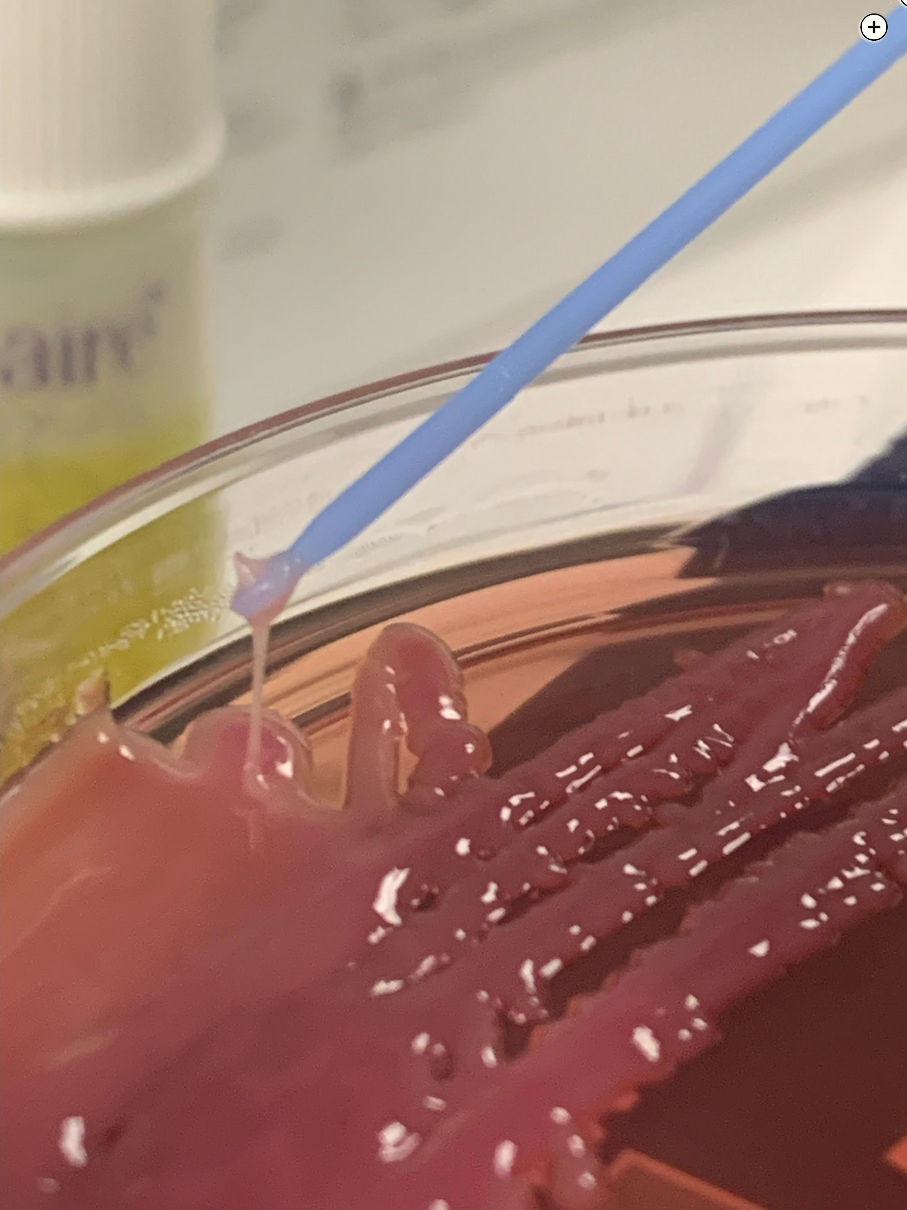

hyperviscous klebsiella pneumoniae
- related: Infectious Disease ID
- tags: #literature #id
Hypervirulent (hypermucoviscous) Klebsiella pneumoniae (hvKp) was discovered in the 1980s but has been increasing in reports over the past 30 years. It most commonly occurs in Asia and the Pacific Islands but can be seen anywhere. Hypermucoviscous hvKp differs from the more common phenotype, classical K pneumoniae, in that it is more virulent and often metastasizes to other organs (including eyes, brain, spleen, lungs, and skin), and it can be difficult to achieve source control. hvKp can be challenging to diagnose but has one distinguishing feature; when grown on an agar plate, the colonies appear hypermucoviscous, and on a string test the inoculation loop or needle can generate a viscous string >5 mm in length (Figure 2). Treatment requires adequate source control, which rarely can be managed with large-bore drains alone and usually requires surgery owing to the viscous and metastatic nature of the organism. As with this case, despite multiple drains, the liver abscess returned and continued to grow, taking up the entire right upper pole of the liver. In addition, this patient developed evidence of metastatic infection in the lungs, with a pattern of a hematogenous spread of the infection in the lower lobes. This patient required a right upper pole partial hepatectomy and 6 weeks of IV antibiotics to obtain source control.

Streptococcus milleri group is a subgroup of viridans streptococci and consists of three distinct species: Streptococcus anginosus, Streptococcus intermedius, and Streptococcus constellatus. These organisms are recognized as normal human flora found in the mouth, throat, stool, and vagina but can lead to pyogenic abscess formation. Although S anginosus can lead to liver abscesses, it typically responds to treatment with drain placement and antibiotics.
Entamoeba histolytica is a protozoan that usually does not produce symptoms but can lead to dysentery. Sometimes it can lead to invasive infections outside the intestines in organs such as the lungs, heart, brain, and liver. Liver abscess is the most common extraintestinal site of infection and is most commonly seen in India, Africa, Mexico, and Central and South America. Diagnosis is made via serologic or antigenic testing and would not be associated with lactose-fermenting gram-negative rods or the string test.
Although Escherichia coli is a gram-negative bacillus and causes liver abscesses, it is not associated with hypermucoviscosity. E coli liver abscesses are also not associated with metastasis to other sites and are responsive to drainage and IV antibiotics.1234
A 34-year-old man is transferred to the ICU with sepsis. He has been admitted to the hospital for the past 2 weeks with an 8.5-cm liver abscess. He initially underwent percutaneous drainage by an interventional radiologist, and cultures from the initial drainage grew mixed organisms. The patient continued to be febrile and tachycardic after drainage so underwent laparoscopic cholecystectomy with drain placement. The liver abscess still did not resolve, so the patient was taken back to the operating room for laparoscopic liver debridement with drain placement 1 day ago.
Since that time, he reports progressive malaise and shortness of breath. At the time of ICU transfer, the patient has a heart rate of 150/min, a respiratory rate of 45/min, and systolic BPs in the 90s. He is supported with high-flow nasal cannula, is receiving IV fluids for resuscitation, and repeat blood cultures have been drawn. He is receiving vancomycin and piperacillin/tazobactam. His laboratory evaluation is remarkable for a creatinine level of 2.76 mg/dL (243.98 μmol/L), mild elevation in transaminase levels, and a lactate level of 5.8 mg/dL (0.64 mmol/L). He underwent CT scanning of the abdomen and pelvis, and the scans were remarkable for an enlarging liver abscess now measuring approximately 12.1 × 11.6 × 10.4 cm (Figure 1). The CT scans also demonstrated bilateral, nodular, peripheral densities in the bases with areas of cavitation (not shown).
On review of culture data from the debridement and drain placement 1 day ago, you note many lactose-fermenting gram-negative rods, and the microbiology laboratory reported that the agar plate is unusually “sticky” (Figure 2).
Which organism is most likely causing this patient’s liver abscess?
Links to this note
Footnotes
-
Although Escherichia coli is a gram-negative bacillus and causes liver abscesses, it is not associated with hypermucoviscosity. E coli liver abscesses are also not associated with metastasis to other sites and are responsive to drainage and IV antibiotics.1 ↩
-
Russo TA, Marr CM. Hypervirulent Klebsiella pneumoniae. Clin Microbiol Rev. 2019;32(3):e00001-19. PubMed ↩
-
Shon AS, Bajwa RP, Russo TA. Hypervirulent (hypermucoviscous) Klebsiella pneumoniae: a new and dangerous breed. Virulence. 2013;4(2):107-118. PubMed ↩